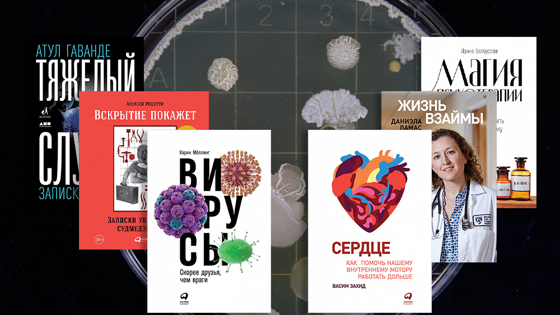

Не гуглится: 6 книг от врачей-практиков
Как только у нас появляется какой-то подозрительный кашель или начинает до красноты чесаться рука, мы начинаем гуглить симптомы, хотя знаем — ничем хорошим это не кончится. Мы собрали для вас 6 книг, которые написали практикующие врачи, чтобы вы лучше поняли свой организм и предотвратили большинство болезней. И чтобы вместо поиска в гугле, сразу записались на приём.Вскрытие покажет О чём книгаЧестные записки судмедэксперта с 16летним стажем — это яркое напоминание, что все мы смертны и нередко сами сокращаем отведённое нам время. Читатели Алексея Решетуна стремительно бросают курить, выпивать и начинают заниматься спортом. Хотя он вовсе не читает мораль: просто показывает, чем все закончится, если продолжать в том же духеЗачем она вамЧтобы вспомнить, что жизнь у нас одна и следить за её благополучием — наша работа. К тому же Алексей Решетун так увлекательно рассказывает о своей практике, что оторваться невозможно. Его рассказ дополняют фотографии, скрытые под QR-кодами, чтобы не травмировать слишком впечатлительных.Жизнь взаймы О чём книгаСовременная медицина спасает от смерти пациентов, которым 10 лет назад могло помочь разве что чудо. Но что делать, если длительное лечение превращается в бесконечное мучение, — терпеть в ожидании улучшения состояния или махнуть рукой на все усилия врачей? Автор книги, врач реаниматолог, пишет, что жизнь спасенного человека часто меняется навсегда. Это касается как его душевного, так и физического состояния.От автора «Когда я пыталась убедить пациента продолжить лечение, мне казалось, что главное — остаться в живых. Пожалуй, так и должен думать врач, только-только начинающий свою карьеру. Но выживание — только начало. Это не черно-белое противопоставление «смерть или жизнь», на самом деле здесь целый спектр возможных вариантов. Сидя на амбулаторных приемах или проверяя показатели госпитализированных больных, я начала задумываться: с чем придется жить этим пациентам после выписки?»Тяжелый случай О чём книгаАтул Гаванде — практикующий хирург, он ежедневно принимает решения, от которых зависит человеческая жизнь, подчас в ситуациях, когда наука ненадёжна, а информации недостаточно. Автор без прикрас рассказывает о своей практике, о врачебных ошибках и смертях пациентов, о медицинских тайнах, которые не получается разгадать, и о чудесах на хирургическом столе.От автора «У вас непрекращающийся кашель — что вы делаете? Обращаетесь не к науке, а к врачу. К врачу, у которого бывают удачные и неудачные дни. К врачу с неприятным смехом и дурной стрижкой. К врачу с еще тремя пациентами на очереди, с неизбежными пробелами в знаниях, с навыками, которые он еще только пытается освоить»Статьи по теме:Цена врачебных ошибокМагия психотерапии О чём книгаСтресс, тревожность, недовольство собой — главные проблемы современного человека. Ирина Белоусова, практикующий психотерапевт и известный блогер, погружает в научную магию психотерапии. Она рассказывает о том, где искать вдохновение; как опознавать уловки мозга и понимать свои чувства; как принимать ситуацию, но вместе с тем ощущать силу и управлять событиями своей жизни.Зачем она вамМы все хотим лучше понимать внутренние мотивы своих поступков, научиться двигаться к своим целям, разбогатеть и поверить в себя. Книга Ирины Белоусовой помогает эти цели найти и протягивает руку помощи, чтобы провести вас через самые разные уголки психики: приятные и не очень. Всё это на живых примерах обычных людей.Сердце О чём книгаМы много говорим о сердце, когда любим, пугаемся, переживаем. Язык придумал много фразеологизмов: «с тяжёлым сердцем», «в сердцах», «предлагать руку и сердце», «как нож в сердце» и много других. Но что мы на самом деле знаем про этот орган? Увлечённый кардиолог Васим Захид написал эту книгу, чтобы мы больше узнали о маленьком моторе, который поддерживает работу нашего тела всю жизнь.Зачем она вамВы узнаете о всех болезнях, которые могут затронуть сердце, а их много. Кардиолог рассказывает, как со всеми ними бороться, когда уже нужно обращаться к врачу и что нужно сделать уже сейчас, чтобы почти все эти болезни предотвратить. А сделать можно многое, ведь наше здоровье зависит только от нас.Статьи по теме:Как пульс связан с продолжительностью жизниКак помочь сердцу работать дольше: 6 советов кардиологаСоветы кардиолога: как сохранить здоровое сердце надолгоВирусы О чём книгаГрипп, ВИЧ, Эбола — мы привыкли думать, что вирусы несут нам только угрозу. Но на самом деле большинство безвредны; более того, они наши незаменимые помощники. Вирусы есть повсюду: в воздухе, растениях и животных, внутри нас самих и даже на нашей коже. Они борются с бактериями, влияют на погоду, наше самочувствие и настроение, способствуют ожирению или лечат от него.Зачем она вамЧтобы перестать шарахаться от слова «вирус» и больше узнать об огромном неизвестном мире вокруг. Из книги вы узнаете, не опасно ли есть салат, откуда на цветах крапинки и можно ли вообще купаться в море. .stk-post [data-anim-name="preset-fadeInLeft"]:not(#stk) { opacity: 0; transform: translate3d(-100%, 0, 0) }